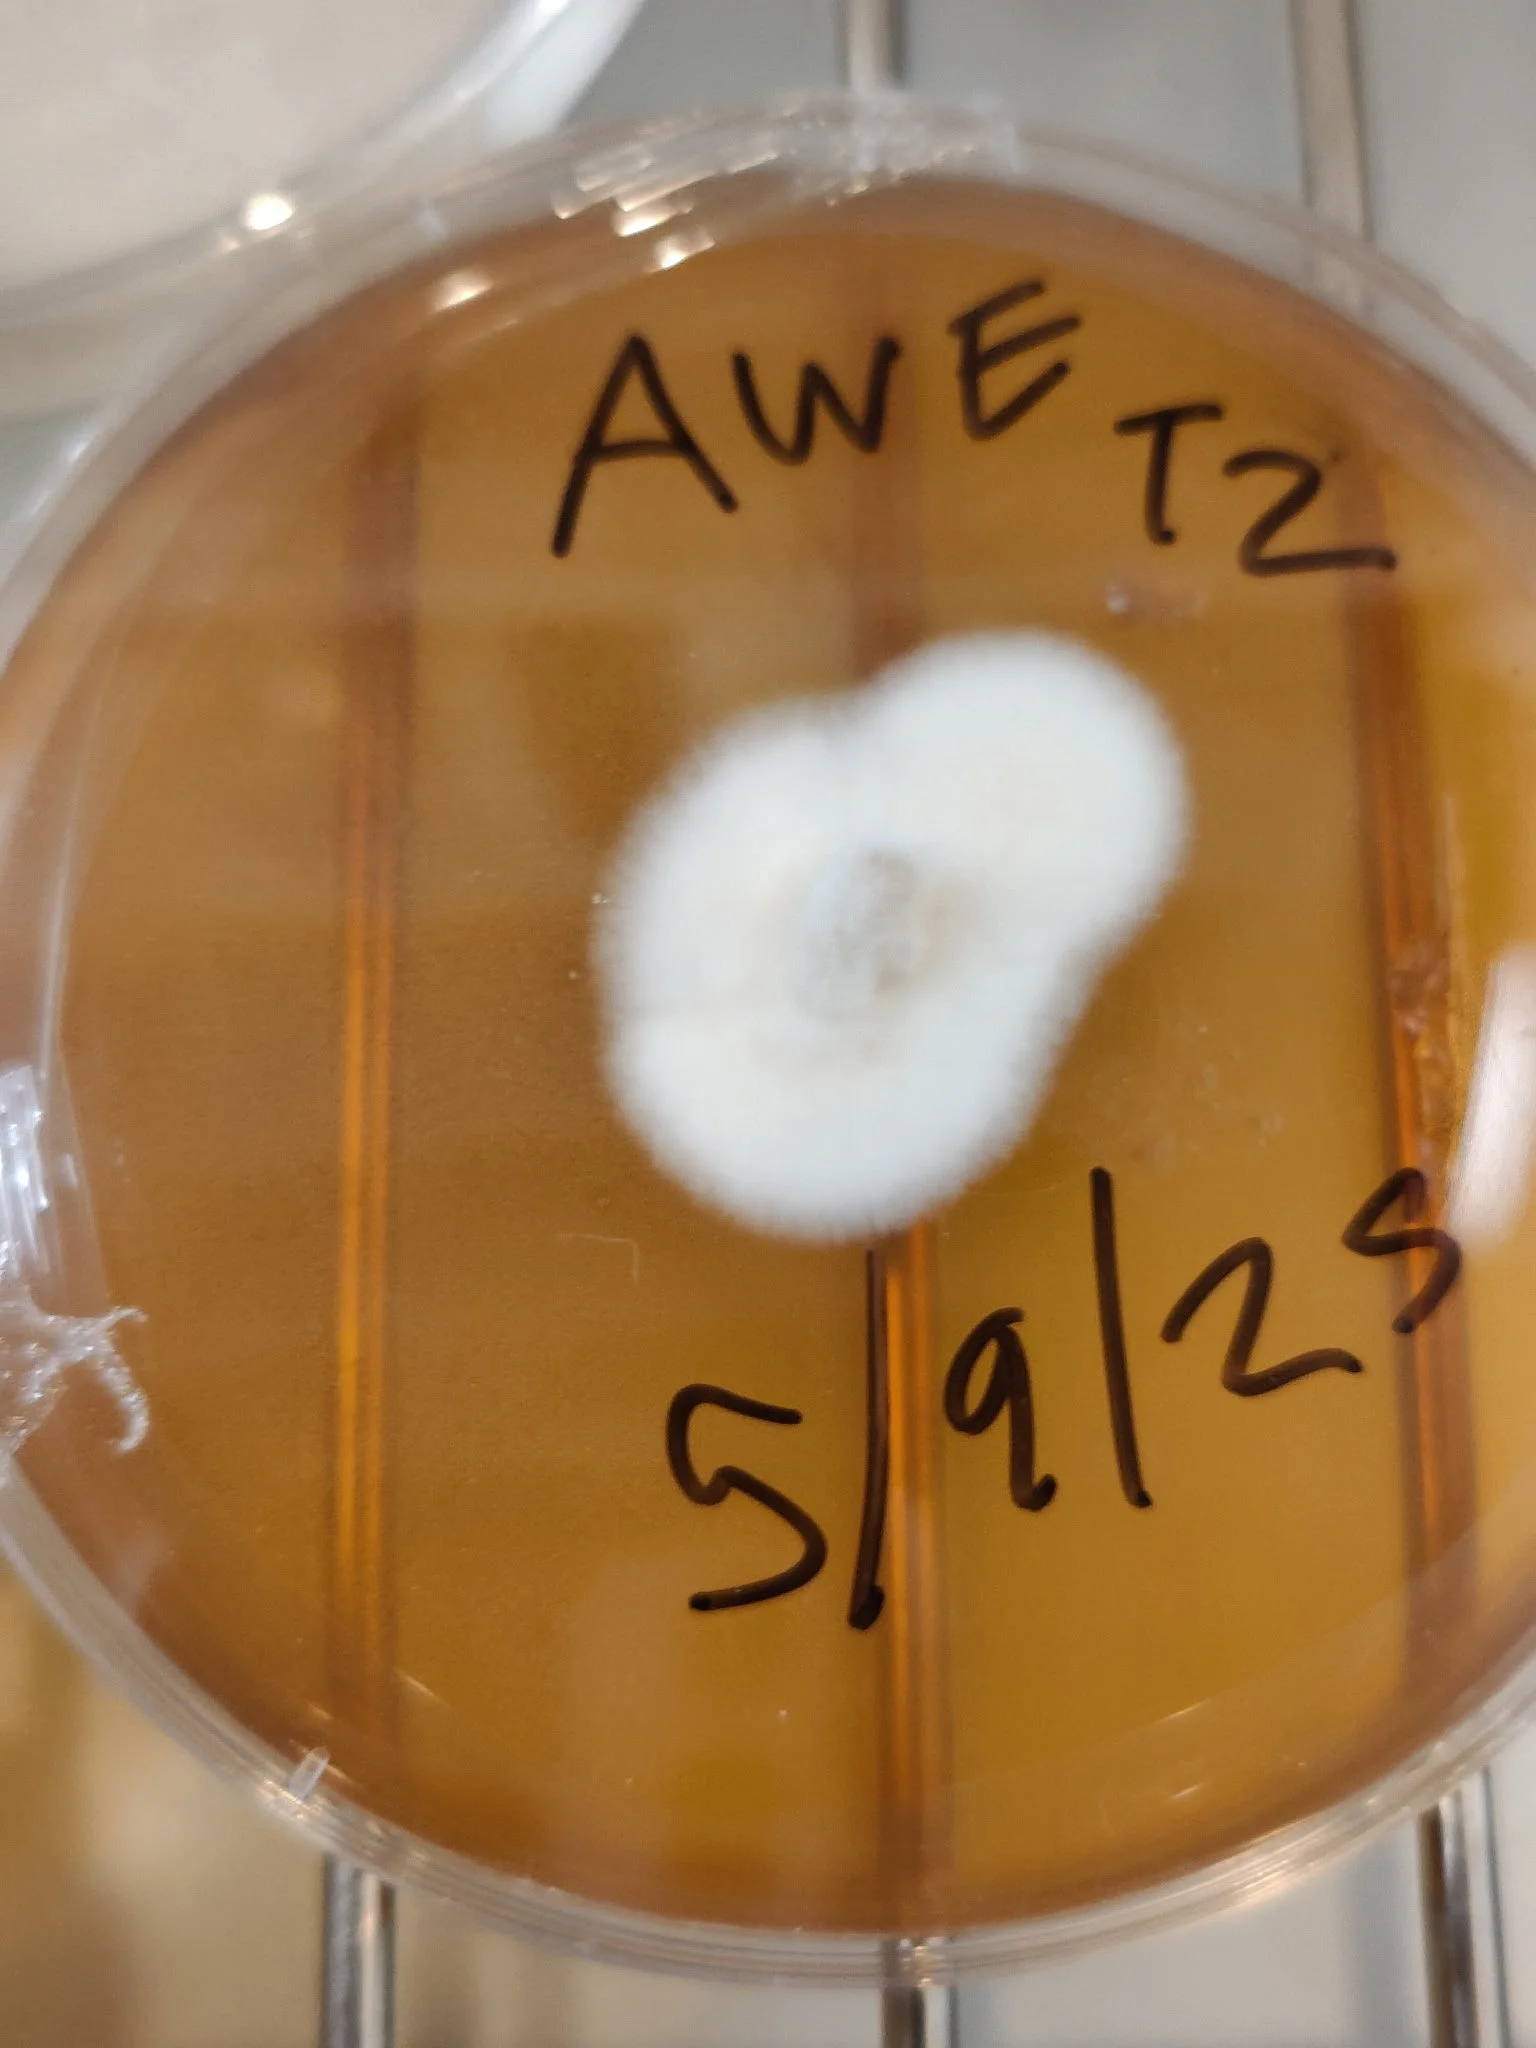
5cbfb79e-868a-44e0-8e1a-e6bf75380727-copied-media~2.jpg (Copy)

YOUR MISSION BRIEFING: WHAT YOU WILL LEARN
We are firing up the grill and ready to grow gourmet mushrooms using some real grill master hacks! In this immersive in-person session, you’ll receive the foundational skills to begin your journey as a Spore Corps Cadet. This class is hands-on, high-vibe, and capped at 15 participants to keep the experience intimate and interactive. You will learn to:
DECODE THE MYCELIAL NETWORK: Understand the basic science and folk wisdom of fungi—how mycelium communicates, adapts, and thrives as a decentralized system much like our own community. Learn what you need to grow both wood loving and dung-loving fungus.
MASTER BASIC INOCULATION PROTOCOLS: We’ll walk step-by-step through how grain spawn and liquid culture work, Austin will demo turning plastic totes into still air boxes and monotubs using heated metal rings, creating smooth holes using a charcoal chimney equipping you with the tools to successfully cultivate mushrooms at home.
IDENTIFY THE KEY STAGES OF THE FRUITING BODY LIFECYCLE: Learn to recognize healthy colonization, contamination risks, and when your mushrooms are ready to fruit. This is where patience meets soft rebellion.
ENGAGE IN COMMUNITY INTELLIGENCE: Experience how Spore Corps operates as a network of growers, sharing resources, knowledge, and support to ensure collective success.
WHAT YOU GET
Every participant will leave with everything they need to begin their first home grow:
Sterilized grain to get you started
Instructions and guidance covered during the session
A deeper understanding of the fungal world and how you can cultivate it yourself
Yummy mushroom snacks from the grill.
This workshop is designed so you can begin your journey the same day you attend.
IS THIS BRIEFING FOR YOU?
This session is designed for:
DIY mycologists and food security advocates ready to weaponize their knowledge.
Gardeners, artists, and educators seeking new, inclusive tools for engagement.
Anyone feeling the call to join the fruiting body of the resistance and decompose the status quo.